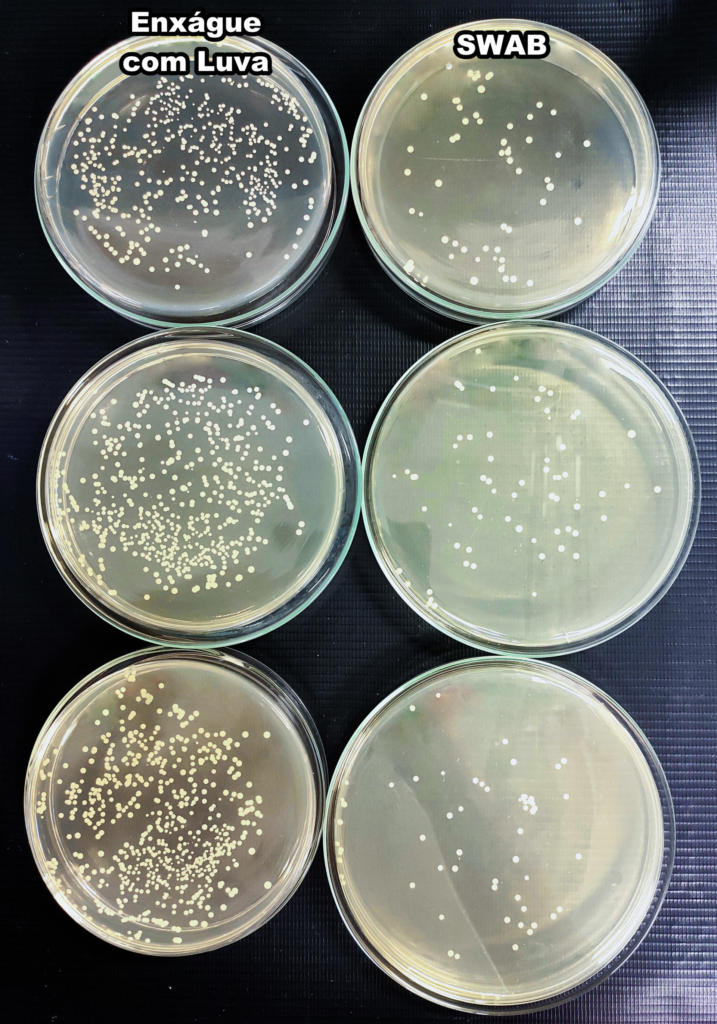

Liliana Berté Fontana é natural de Putinga, que fica na Região do Vale do Taquari/RS. Em 2017, mudou-se para Palmeira das Missões para estudar Ciências Biológicas em um dos campi da Universidade Federal de Santa Maria. Na graduação, a acadêmica experienciou diferentes laboratórios: primeiro, na área de botânica; depois, participou do PIBID – Programa Institucional de Bolsa de Iniciação à Docência – e do Laboratório de Primatologia; por fim, entrou no Laboratório de Microbiologia, onde desenvolveu o Trabalho de Conclusão de Curso (TCC).
Com a temática da higiene das mãos, Liliana iniciou o TCC em 2019, no quarto semestre da faculdade. O projeto foi feito no primeiro semestre daquele ano, e a prática no segundo, o que envolveu observações da adesão à higiene das mãos no Hospital de Caridade de Palmeira das Missões, coleta microbiológica para análise dos micro-organismos e teste de sensibilidade a antibióticos. Após essas etapas, ela levou os resultados ao hospital, além de realizar um treinamento com os profissionais no início de março de 2020, pouco antes da pandemia chegar ao Brasil e das aulas presenciais da UFSM serem suspensas. A formação educativa, que fazia parte dos objetivos do trabalho, contribuiu para o enfrentamento da pandemia pelo hospital.
Recentemente, Liliana entrou para a equipe do Detecta, laboratório da UFSM que realiza testes de Covid-19, sequenciamento para detecção do vírus e treinamentos para profissionais de diferentes municípios. A Revista Arco entrevistou Liliana para saber mais sobre a pesquisa, os resultados do trabalho e a premiação no evento de imunologia da Universidade de São Paulo – USP.
Revista Arco: Por que a higienização das mãos é uma precaução universal?
Liliana: Teve um médico, Ignaz Semmelweis, que estudou a adesão à higiene das mãos. Foi o primeiro que percebeu a importância da higienização. Mesmo após 174 anos dessa descoberta para a prevenção de doenças infecciosas, nós temos dificuldade de fazer com que a população entenda a importância da higiene. Muitas pessoas negligenciam essa prática tão essencial. Ela é uma prática universal e já confirmada há muitos anos, que, além de barata, possui importância extrema para contenção de doenças, contenção de pandemias, para contenção da disseminação de micro-organismos e de patologias, que muitas vezes podem ser muito resistentes.

Revista Arco: Tem a ver com o fato de usarmos as mãos para tudo e termos o costume de colocá-las no cabelo e no rosto?
Liliana: As mãos são a principal ferramenta de trabalho da maioria das pessoas. Estão em contato com diversas superfícies: cumprimentamos as pessoas com as mãos, nos alimentamos com as mãos, as utilizamos para realizar todas as nossas atividades diárias, tanto pessoais quanto profissionais. Muitas vezes também estamos mexendo no cabelo, coçando, limpando o olho, limpando a boca, limpando o nariz – então é um meio que entra em contato com tudo, com diversas superfícies, com diversas pessoas e também com nós mesmos.
É tanto uma precaução para nossa saúde quanto para saúde das outras pessoas, porque a gente pode passar os nossos micro-organismos para os outros. A gente sabe que os micro-organismos estão por todas as áreas do nosso corpo, por toda a superfície da pele, mas existem algumas regiões que podem concentrar micro-organismos que apresentam mais possibilidades de serem patogênicos. Para garantir a sua própria segurança e segurança das pessoas ao seu redor, a higiene das mãos é uma medida que vai auxiliar nesse processo.
Revista Arco: O seu trabalho foi feito antes da pandemia. Você considera que ele ganhou mais relevância, não só no sentido de repercussão, mas de importância, pelo fato de termos entrado em um período em que higienizar as mãos se tornou um protocolo?
Liliana: Sim, com certeza. Eu acredito que as pessoas sabem da importância, mas o problema é que acabam negligenciando: a gente pensa que não encostou em nada, eu olho para as minhas mãos e elas não estão sujas, não tenho a sensação de sujidade. Não é como quando eu tomo um sorvete e tenho a sensação de que as mãos estão grudentas. Os micro-organismos não dão essas sensações, a gente não consegue enxergar, então pode ser que a mão esteja totalmente contaminada, mas a sensação é de limpeza. Eu acredito que, com a pandemia, isso foi enfatizado. Como as pessoas contraem algo que não conseguem ver? Essa é a prova de que sim, os micro-organismos estão no ambiente, nas mãos, no corpo, em todos os locais. A gente não enxerga, mas eles podem causar doenças e problemas para a saúde das pessoas. Então, higienizar as mãos contempla tanto a pandemia da Covid-19 e elimina o Sars-Cov 2 quanto outros micro-organismos que também são vinculados a infecções, a casos de internação hospitalar e até casos de morte. A higiene das mãos ajuda a diminuir a carga viral, a carga bacteriana e microbiológica.

Revista Arco: Como foi feita a aplicação do seu estudo no Hospital de Caridade de Palmeira das Missões?
Liliana: O trabalho consistiu em 45 horas de observação da adesão à higiene das mãos. Eu fiquei num ponto específico do setor de clínica médica, que é o de maior número de internações do hospital. Fiquei lá observando os profissionais de saúde durante o seu dia de trabalho. Eu não falei pra eles o que estava observando para não influenciar nos resultados, e tinha uma prancheta com informações, com momentos e oportunidades para higiene das mãos que são recomendados pela Anvisa. Eu ficava observando e anotando se a adesão foi realizada ou não foi realizada.
Eu não observava as pessoas, eu observava as oportunidades de higienização. Com esse trabalho, eu encontrei 791 oportunidades, e dessas, 16,18% foram aderidas. Esse número é baixo se pensar que, das cem vezes que tive oportunidade de higienizar as mãos, higienizei só em dezesseis. Mas isso é encontrado em outros estudos, principalmente quando se trata de hospitais de pequeno porte. A adesão mundial está em média de 5% a 40%.
Eu percebi que não tinha dispensers de álcool gel nos quartos, e poucos quartos tinham banheiro. Quando o profissional entrava no quarto e atendia ou tocava no paciente, para higienizar as mãos precisaria sair do quarto e ir até o posto de enfermagem ou até o corredor, que tinha um dispenser de álcool em gel. Os profissionais de enfermagem já têm uma carga horária bem alta e uma demanda grande de trabalho. Além de ter pouco tempo, eles tinham que fazer todo esse trajeto. Imagina o tempo que perdiam. Esse é um dos principais motivos para a adesão ser baixa.
Essa [as observações] foi a primeira parte do trabalho. Além disso, foi aplicado um questionário com questões fechadas relativas aos conhecimentos da higiene das mãos. Foi pedido dos profissionais quantos treinamentos eles já tinham realizado, se conheciam as normas da Anvisa, quais micro-organismos eles acreditavam existir nas mãos, porque eles higienizavam ou não as mãos.
A partir disso realizamos coletas microbiológicas. Os profissionais colocaram a mão dominante dentro de um saco contendo uma solução meio de transporte.
Revista Arco: O que seria a solução meio de transporte?
Liliana: Esse meio de transporte é um líquido que vai manter os micro-organismos viáveis, vai manter eles vivos até serem levados para o laboratório, para que depois eu possa fazer a análise. Além disso, essa solução não vai influenciar na reprodução: ela não contém os nutrientes ideais para algum crescimento dos micro-organismos, só para evitar que eles morram. Era uma solução salina, com água destilada e uma concentração de sal de 0,1%.
Os profissionais colocavam a mão dentro do saco e faziam movimentos para que o líquido passasse por toda a superfície da mão, durante um minuto. Depois disso, levamos todos esses sacos, essas amostras, pro laboratório de microbiologia, e realizamos todos os procedimentos microbiológicos para analisar quais micro-organismos tinham e em qual quantidade.

Revista Arco: A ação de mergulhar a mão no saco e mexê-la ali dentro é para que os micro-organismos presentes na mão soltassem, o saco era fechado e levado pro laboratório, é isso?
Liliana: Isso. É uma técnica onde esse líquido vai passar pela superfície das mãos e vai fazer com que esses micro-organismos se desprendam para a solução. Obviamente não vão passar todos os micro-organismos. Existem outros métodos de coleta e análise, como por exemplo o swab, o mesmo que a gente faz com os testes de Covid, porém esse método acaba espalhando os micro-organismos nas mãos e, como a mão é uma superfície relativamente grande, a recuperação de micro-organismos é um pouco mais baixa. Enquanto o swab recupera aproximadamente 1,9% dos micro-organismos da mão, o saco consegue recuperar mais de 40%. Além de recuperar mais micro-organismos, ele consegue recuperar uma diversidade maior porque, com esses movimentos dentro do líquido, além de desprender os micro-organismos da microbiota transitória, é possível desprender os micro-organismos da microbiota residente – que fica numa camada um pouco mais inferior da pele, e que com o swab é mais difícil de ser atingida.
Revista Arco: Uma das técnicas que você utilizou é a contagem padrão em placas. Pode explicar o que ela é e como funciona?
Liliana: Essa é uma técnica de contagem. O que acontece: os micro-organismos formam colônias, e só conseguimos as observar quando houver uma quantidade “x” de micro-organismos unidos, até porque eles são invisíveis a olho nu. Mas quando eles crescem num meio de cultura que tem os nutrientes ideais pro crescimento, eles vão formando colônias, que parecem um conjunto de bolinhas. Nós fazemos a contagem dessas bolinhas para fazer todos os cálculos e saber quantos micro-organismos estavam presentes na mão dessa pessoa. Fazemos todo esse processamento, essa semeadura dos micro-organismos, dentro de uma placa, contendo um meio de cultura, com todos os nutrientes ideais pro crescimento deles. Colocamos na estufa em uma temperatura ideal – que é a temperatura do nosso corpo, 37 graus – e deixamos ali de 24 a 48h.
Depois desse tempo, observamos a placa e vemos se os micro-organismos cresceram ou não, se cresceram, quanto? Cada micro-organismo vai crescer em um meio diferente. Eu analisei fungos, bactérias aeróbias mesófilas, que são bactérias que vivem com a presença de ar, geralmente estão na superfície do nosso corpo, na superfície do ambiente. Também observei estafilococos, dentro deles eu identifiquei os estafilos aureus, que são os micro-organismos mais vinculados às infecções hospitalares.
Após a identificação, fizemos testes de sensibilidade a diferentes antibióticos utilizados no hospital, para ver se eles eram resistentes ou sensíveis.
Revista Arco: Quais são os principais resultados do seu trabalho?
Liliana: Depois de todo o processo de observação, analisamos os resultados, fomos para o hospital e os apresentamos para a direção e para o controle da comissão hospitalar. Apontamos que implementações estruturais precisariam ser feitas, e que havia a necessidade de desenvolver treinamentos. Em março [2020], realizamos o primeiro treinamento com os profissionais. Depois, foram feitos outros treinamentos, mas pro meu TCC foi apenas esse primeiro, os outros foram consequência.
Com a pandemia, depois de todos os treinamentos e dos profissionais e da direção saberem o número do nível de adesão, foi possível serem tomadas medidas para analisar porque a adesão estava baixa, o que teria que melhorar. Foram implementados dispensers de álcool em gel nos quartos do setor de clínica médica, através de doações – nós arrecadamos o dinheiro -, e foi implementado outro lavatório, já que só havia um no posto de enfermagem.
A higiene das mãos é uma medida essencial para contenção de eventos pandêmicos, para contenção de disseminação de micro-organismos, e é uma medida extremamente simples, prática, barata e eficaz, que pode ser realizada em qualquer local, por qualquer pessoa. É necessário uma maior conscientização, tanto para população quanto com os profissionais de saúde. É preciso haver treinamentos frequentes nos hospitais para enfatizar, porque podemos escutar algo mil vezes, mas sempre aprendemos algo novo.
Revista Arco: Pode contar como foi participar do evento da USP?
Liliana: Foi algo muito positivo para a minha formação. Tinha muitos inscritos, ao todo foram 780 inscritos, e foram selecionadas 60 pessoas. E eu fiquei entre essas 60. Foram duas semanas de palestras, sendo que participaram os professores do Programa de Imunologia, e também acadêmicos, mestrandos, doutorandos, egressos da instituição, do curso, da especialização. A experiência foi muito positiva e, além disso, eu pude conhecer outra instituição – tão almejada e tão disputada no nosso país.
Revista Arco: E qual foi a sensação de saber que você ganhou o prêmio?
Liliana: Foi muito boa. Uma sensação de que realmente o meu trabalho fez a diferença, de que é relevante. Foi algo bom porque eu já tinha essa sensação, eu já tinha recebido elogios, agradecimentos do hospital. Claro que eu sou muito grata a eles porque, sem eles, eu não teria feito nada, a confiança foi essencial. O prêmio foi só um motivo a mais para me deixar mais orgulhosa. Também sinto gratidão pela UFSM, porque ela é uma instituição extremamente importante, não só pra mim mas para diversos estudantes – é uma instituição pública, gratuita e possui uma extrema qualidade. Tanto a minha orientadora quanto todos os outros professores que eu tive durante a graduação sempre incentivaram essa parte de extensão, de apresentação dos trabalhos de escrita científica. Se eu consegui conquistar tudo isso, consegui tantos reconhecimentos, foi porque eu tive bons professores.
Expediente
Reportagem: Samara Wobeto, acadêmica de Jornalismo e bolsista
Ilustração: Luiz Figueiró, acadêmico de Desenho Industrial e voluntário
Mídia Social: Eloíze Moraes, acadêmica de Jornalismo e bolsista; e Caroline de Souza, acadêmica de Jornalismo e voluntária
Edição de Produção: Esther Klein, acadêmica de Jornalismo e bolsista
Edição Geral: Luciane Treulieb e Maurício Dias, jornalistas



